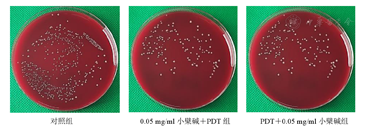

探讨亚甲基蓝介导的光动力疗法(PDT)联合小檗碱对牙龈卟啉单胞菌(P.g)的体外抑制作用。
培养P.g至对数期中后期,将不同质量浓度亚甲基蓝加入P.g菌悬液中,作用5 min,激光(波长660 nm,功率140 mW/cm2)照射2 min,寻找亚甲基蓝结合激光体外抑制P.g的最佳浓度;观察亚甲基蓝介导的PDT体外抑制P.g的效果以及小檗碱对P.g生长曲线的影响;探讨亚甲基蓝介导的PDT与小檗碱先后联合应用对P.g的抑制作用;扫描电子显微镜观察亚甲基蓝介导的PDT及小檗碱对P.g形态的影响;紫外分光光度仪测量各成分吸收峰。
在660 nm激光激发下,亚甲基蓝质量浓度为24.414 1 μg/ml时,抑菌效果最好。与对照组比较,亚甲基蓝组和PDT组差异均有统计学意义(均P<0.001)。0.05 mg/ml小檗碱对P.g浮游细菌具有抑制作用。与对照组比较,0.05 mg/ml小檗碱组菌落数降低,其差异有统计学意义(P<0.01);0.05 mg/ml小檗碱+光照组与对照组比较差异无统计学意义(P>0.05)。当PDT与小檗碱联用时对P.g有协同抑制作用,且先PDT后小檗碱组较先小檗碱后PDT组菌落数降低,其差异均有统计学意义(均P<0.01)。P.g经亚甲基蓝介导的PDT处理后,细菌细胞壁皱缩成团,经小檗碱处理后,细菌表面变得光滑且菌体长度较对照组增长。
亚甲基蓝介导的PDT对P.g有抑制作用,当与小檗碱联用时,对P.g有协同抑制作用,且联合应用中先PDT后小檗碱作用时抑菌效果更好。
版权归中华医学会所有。
未经授权,不得转载、摘编本刊文章,不得使用本刊的版式设计。
除非特别声明,本刊刊出的所有文章不代表中华医学会和本刊编委会的观点。
牙周炎是口腔中最常见的慢性感染性疾病,以牙菌斑为始动因子,通常会引起炎症和牙周支持组织的减少,是成人失牙最主要的原因[1]。在危害口腔健康的同时,还增加了罹患全身其他系统性疾病如糖尿病、阿尔茨海默症、冠心病和呼吸道疾病等的风险。牙龈卟啉单胞菌(Porphyromonas gingivalis,P.g)是牙周疾病中最重要的机会致病菌,且不易被免疫系统和药物清除[2]。目前,牙周炎的治疗方法主要包括机械治疗和药物治疗,但都有一定的局限性。因此,应致力于研究新的对抗牙周炎细菌的治疗策略。
光动力疗法(photodynamic therapy,PDT)是治疗耐药细菌的一种很有前景的方法,由光、光敏剂和氧分子3部分组成。其原理为一定波长的光激发光敏剂,释放的能量与氧分子发生反应形成自由基与活性氧,进而发挥非特异性的杀伤作用。PDT对许多牙周病原体的毒性作用已得到证实。除抑菌作用外,PDT可诱导牙周炎中过度增殖的巨噬细胞发生凋亡,并抑制牙槽骨吸收[3]。但关于PDT在牙周病学中应用的临床数据仍有限,支持PDT作为牙周炎治疗辅助手段的证据尚不充分[4,5]。因此,需要更多的理论支持。小檗碱是复方黄连素片的主要成分,是一种异喹啉生物碱,是草本植物中浓度最高的生物碱。它具有抗氧化、抗炎、抗糖尿病、抗微生物和抗癌等特性。小檗碱可以pH依赖的方式直接与生物体DNA结合,从而影响细胞周期造成破坏[6],还可作为细菌耐药泵抑制剂提高药物疗效[7]。有研究表明小檗碱是一种光敏剂,在存在光源的情况下能够产生活性氧和其他自由基[8],且其对P.g有抑制作用[9]。本研究为探讨以亚甲基蓝介导的PDT对P.g的抑制作用,且与小檗碱联合使用时对抑菌作用的影响,并探讨具有光敏性、耐药泵抑制剂的药物对依赖光敏性能的PDT的影响,探究不同使用顺序对PDT疗效的影响,以期为临床提供指导建议。
实验菌株P.g(货号ATCC33277)由广州医科大学口腔实验室赠予,经16S RNA鉴定为P.g纯种菌。亚甲基蓝(北京索莱宝科技有限公司),盐酸小檗碱(北京索莱宝科技有限公司,HPLC测定质量分数≥98%),厌氧培养袋、厌氧产气袋(日本三菱瓦斯化学株式会社),脑心浸液肉汤培养基(brain heart infusion medium,BHI,青岛海博生物有限公司),氯高铁血红素、维生素K1(美国Sigma-Aldrich公司),哥伦比亚血琼脂培养基(贝瑞特生物技术有限公司);哌威激光口腔治疗仪(郑州哌威电子科技有限公司),UV-2700系列紫外可见分光光度计(日本岛津公司),SU8010生物扫描电子显微镜(日本Hitachi公司)。
将P.g复苏于哥伦比亚血平板上,37 ℃厌氧培养5~7 d,至对数期中后期,用接种环刮下细菌转移至新鲜BHI培养基中(含有1%氯化血红素和0.1%维生素K1),厌氧培养过夜,可见菌液呈现浑浊状态。革兰染色鉴定为革兰阴性菌,紫外分光光度仪调整细菌吸光度(A)值为1,稀释细菌菌液浓度至104 cfu/ml,用于后续实验。
每孔100 μl菌液加入96孔板中,然后加入不同质量浓度(0、1.525 9、6.103 5、24.414 1、97.656 3、390.625、1 562.5、6 250、25 000、100 000 μg/ml)亚甲基蓝,避光孵育5 min,激光(波长660 nm,功率140 mW/cm2)照射2 min。吸取20 μl,处理后的菌液,于4~5 cm高度处滴在哥伦比亚血平板上,用涂布棒涂开,37 ℃厌氧条件下培养5~7 d,计算菌落数,观察不同质量浓度亚甲基蓝对PDT效果的影响,实验至少重复3次,选择最佳浓度进行后续实验。
设置对照组、光照组、亚甲基蓝组、PDT组和米诺环素组,对照组只给予原始菌液,光照组在原始菌液上仅给予光照,亚甲基蓝组在原始菌液上仅给予24 μg/ml亚甲基蓝,PDT组在原始菌液上给予光照和亚甲基蓝,米诺环素组在原始菌液上给予24 μg/ml米诺环素。吸取20 μl处理后菌液涂布于哥伦比亚血平板,37 ℃厌氧条件下培养5~7 d,实验至少重复3次。
将过夜培养14~18 h的P.g加入新鲜BHI培养基,调整A值至0.2,加入小檗碱使其终质量浓度分别为0、0.05 mg/ml。将上述菌液放入37 ℃培养箱,厌氧培养48 h,每隔4 h取100 μl菌液测1次A值,以新鲜BHI培养基为调零孔,此实验重复2次取平均值,描绘出生长曲线。
A小檗碱=A菌液-A新鲜BHI培养基
将稀释后的菌液加入48孔板中,设置对照组、0.05 mg/ml小檗碱组、0.05 mg/ml小檗碱+光照组、先小檗碱后PDT组(0、0.03、0.05、0.10 mg/ml小檗碱+PDT组)和先PDT后小檗碱组(PDT+0、0.03、0.05、0.1 mg/ml小檗碱)。对照组只给予原始菌液,0.05 mg/ml小檗碱组用小檗碱作用30 min,0.05 mg/ml小檗碱+光照组先用小檗碱孵育5 min后,激光(波长660 nm,功率140 mW/cm2)照射2 min;先小檗碱后PDT组:先在各孔中加入小檗碱,使小檗碱终质量浓度分别为0、0.03、0.05、0.1 mg/ml,置于厌氧袋中培养30 min,后加入亚甲基蓝避光孵育5 min,激光(波长660 nm,功率140 mW/cm2)照射2 min;先PDT后小檗碱组:各组中先加入亚甲基蓝避光孵育5 min后,激光(波长660 nm,功率140 mW/cm2)照射2 min,后在各孔中加入不同质量浓度小檗碱,使小檗碱终质量浓度为0、0.03、0.05、0.1 mg/ml。放入厌氧袋中,30 min后吸取菌液铺板。吸取20 μl处理后菌液涂布于哥伦比亚血平板,37 ℃厌氧条件下培养5~7 d,实验至少重复3次。
设置对照组、小檗碱组、PDT组,将过夜培养的菌液稀释至108 cfu/ml,各组分别取10 ml加入15 ml无菌试管中,对照组仅加入菌液,不做其他处理;小檗碱组加入小檗碱调整质量浓度至0.05 mg/ml,37 ℃厌氧培养4 h;PDT组亚甲基蓝孵育5 min,激光(波长660 nm,功率140 mw/cm2)照2 min。各组菌液在4 ℃下离心10 min(转速5 000 r/min,离心半径10 cm),弃上清,PBS清洗沉淀3次。加入2.5%戊二醛,固定过夜,乙醇梯度脱水,临界点干燥。使用电子扫描显微镜观察P.g形态。
设置小檗碱(0.05 mg/ml)组、亚甲基蓝(24 μg/ml)组和小檗碱(0.1 mg/ml)+亚甲基蓝(48 μg/ml)组。上述溶液各吸取500 μl混合至EP管中。紫外分光光度仪测量各成分吸收峰,以灭菌双蒸水为调零对照孔。
所有实验都进行至少3次重复,计算独立重复的平均值,并使用GraphPad Prism 9.4.0软件进行处理。通过方差分析和Tukey-Kramer范围进行检验。以P<0.05为差异具有统计学意义。
如图1所示,当亚甲基蓝质量浓度为6 250 μg/ml时,开始有细菌生长;当亚甲基蓝质量浓度为24.414 1 μg/ml时,抑菌效果最好且亚甲基蓝浓度最低,其差异有统计学意义(P<0.05)。


1—对照组;2~11—0、1.525 9、6.103 5、24.414 1、97.656 3、390.625、1 562.5、6 250、25 000、100 000 μg/ml亚甲基蓝组;PDT—光动力疗法。aP<0.05
如图2所示,光照组的菌落数与对照组比较差异无统计学意义(P>0.05),说明单独光照对杀伤P.g没有影响;亚甲基蓝组和PDT组与对照组比较差异均有统计学意义(均P<0.001),米诺环素将细菌完全杀灭。


1—对照组;2—光照组;3—亚甲基蓝组;4—PDT组;5—米诺环素组;PDT—光动力疗法;P.g—牙龈卟啉单胞菌。aP<0.001
由图3可知,0.05 mg/ml小檗碱对P.g浮游细菌具有抑制作用。


P.g—牙龈卟啉单胞菌
由图4、图5可知,与对照组比较,0.05 mg/ml小檗碱组菌落数降低,其差异有统计学意义(P<0.01);0.05 mg/ml小檗碱+光照组与对照组比较差异无统计学意义(P>0.05)。先PDT后小檗碱组较先小檗碱后PDT组菌落数降低,其差异均有统计学意义(均P<0.01)。说明先PDT后小檗碱对P.g的抑制作用优于先小檗碱后PDT组,药物与PDT联合应用抑菌效果优于单独用药物组。


1—对照组;2—0.05 mg/ml小檗碱组;3—0.05 mg/ml小檗碱+光照组;4—0 mg/ml小檗碱+PDT组;5—PDT+0 mg/ml小檗碱组;6—0.03 mg/ml小檗碱+PDT组;7—PDT+0.03 mg/ml小檗碱组;8—0.05 mg/ml小檗碱+PDT组;9—PDT+0.05 mg/ml小檗碱组;10—0.1 mg/ml小檗碱+PDT组;11—PDT+0.1 mg/ml小檗碱组;PDT—光动力疗法;P.g—牙龈卟啉单胞菌。aP<0.01;bP<0.001

PDT—光动力疗法
由图6可知,对照组细菌呈长杆状,表面粗糙呈颗粒状,结构均一。与对照组比较,PDT组细菌表面皱缩,聚集成团;小檗碱组细菌表面颗粒状物质消失,较光滑,且整体长度增长。


PDT—光动力疗法;P.g—牙龈卟啉单胞菌
由图7可知,小檗碱(0.05 mg/ml)组的吸收峰值在230、265、345 nm附近,亚甲基蓝(24 μg/ml)组的吸收峰值在300、550~700 nm附近,小檗碱(0.1 mg/ml)+亚甲基蓝(48 μg/ml)组的吸收峰值在200~400、550~700 nm附近。


抗菌PDT从发明至今,受到了越来越多人的重视,应用领域也逐步扩大。PDT有很多优点,可通过多种途径来杀死细菌,如结合细菌脂质、核酸、蛋白质等[10]。其吸收位点具有特异性且不产生耐药性。不产生耐药性的原因有:药物光照间隔太短,细菌无法产生耐药性;细菌不必参与针对光敏剂的适应性生存机制;PDT后细菌受损严重,无法进行传代;PDT针对细菌的不同位点产生破坏,难以产生耐药性[11]。
化合物与光的相互作用可导致单线态氧和自由基物质的产生,这种化合物称为光敏剂。光敏剂在氧气存在和光刺激下产生超氧自由基(Ⅰ型反应),进而可能形成过氧化物和羟基自由基,或单线态氧分子(Ⅱ型反应)[12]。实验所用的光敏剂为亚甲基蓝,其是获得临床批准的光敏剂之一,在550~700 nm处显示强吸收峰,与本实验中测定结果相似。亚甲基蓝在浮游细菌中表现出良好的杀菌效果。研究表明,亚甲基蓝本身就具有毒性,能够抑制大肠杆菌、铜绿假单胞菌、白色念珠菌等细菌的生长[13,14]。本实验中,高浓度的亚甲基蓝产生明显的杀菌效果,可能是以亚甲基蓝为主的抗菌作用所致,而不是PDT的抗菌作用所致。在设定浓度范围内,当亚甲基蓝质量浓度为24 μg/ml时,其介导的PDT对P.g有较好的抑菌效果。PDT作为单一疗法的杀菌作用不随光敏剂浓度的增加而增加,可能是因为亚甲基蓝是一种氧化还原物质,具有一定的氧化性,能够黏附活体细菌,当亚甲基蓝浓度超过一定数值时,能够和细菌表面某些物质发生氧化反应,反而起到了保护细菌的作用。研究表明,0.1 μmol/ml(31.985 μg/ml)亚甲基蓝介导的PDT对人牙周膜成纤维细胞产生1级细胞毒性。本实验中使用的亚甲基蓝质量浓度为24 μg/ml,对细胞毒性作用相对较小[15]。
在PDT体外杀灭P.g实验中,亚甲基蓝组和PDT组与对照组比较差异均有统计学意义(均P<0.001)。亚甲基蓝可以结合P.g的部分蛋白,光照时亚甲基蓝产生的活性氧可以破坏这些蛋白,导致细菌死亡。除此之外,亚甲基蓝可以潜在地干预P.g核苷酸的合成和代谢,进而抑制其增殖[16]。研究表明,在没有光敏剂存在的情况下,单独光照也会影响P.g细胞的活力[17]。P.g细胞壁中的内源性卟啉可以充当天然光敏剂,卟啉可以被特定波长的光化学激发,并促进活性氧的产生。在使用波长为380~520 nm,功率密度为70 mW/cm2时,培养基中的P.g存活率很容易降低90%以上[18]。同样,在使用类似功率密度71.7 mW/cm2,660 nm的红光照射28 min后,P.g减少了1.33 lg cfu/ml[19]。本实验中单独光照组与对照组比较差异无统计学意义(P>0.05),可能为实验所用激光强度及所用时间不足以杀灭P.g。有研究表明,使用532 nm的激光照射荧光素(538 nm)、赤藓红(526 nm)和玫瑰红(549 nm)3种光敏剂,只有玫瑰红渗入细菌效率最高且发挥了PDT效应[20]。因此,PDT效应不完全取决于光敏剂种类及光照射波长,还与光敏剂化学结构及对细菌的渗透能力有关。
细菌的灭活取决于光敏剂与病原体的结合即光敏剂与细菌细胞表面的结合或相互作用。革兰阳性和革兰阴性细菌表面都整体带负电[21]。因此,充当阳离子的光敏剂(如亚甲基蓝)与细菌表面相互吸引,能更有效地结合细菌并被细菌吸收[22]。P.g为革兰阴性菌,相较于革兰阳性菌,革兰阴性菌有双层的脂双层结构,这导致它们的渗透性较低,限制了光敏剂简单扩散到细菌细胞质中。当细菌对光敏剂吸收不足时会影响PDT的抗菌效果[10]。因此,PDT对革兰阴性菌的杀灭效果不如革兰阳性菌强[23]。
鉴于此,本实验将PDT与小檗碱联合使用,探究其对P.g的抗菌作用。目前,抗生素是治疗细菌感染应用最为广泛的方法,本实验观察到,经亚甲基蓝介导的PDT处理后,细菌细胞壁皱缩成团,可能是PDT使细菌细胞壁损伤,细菌裂解所致。经小檗碱处理后,细菌表面变得光滑且菌体长度较对照组增长,这可能与小檗碱作用于细菌细胞周期相关。本实验测得0.05 mg/ml小檗碱的最大吸收峰在230、265、345 nm附近。因此,小檗碱可能是用于PDT的潜在光敏剂,可提高治疗效率并最大程度地减少不良反应。此外,小檗碱可诱导细胞周期停滞,作为耐药泵抑制剂增强药物疗效,抑制细胞增殖和迁移以及刺激各种癌细胞系中的细胞凋亡[24,25]。
本实验中,当PDT与小檗碱联合应用时,抑菌效果均比单独使用小檗碱效果好。图4中0 mg/ml小檗碱+PDT组和PDT+0 mg/ml小檗碱组均仅使用PDT,但抑菌效果有差异的原因可能为PDT+0 mg/ml小檗碱组中细菌经PDT作用后,亚甲基蓝持续存在30 min,亚甲基蓝本身的毒性作用将P.g部分杀灭。小檗碱+光照组中,以小檗碱作为光敏剂,使用660 nm激光激发时,P.g浮游细菌并未减少,原因可能为小檗碱吸收峰在400 nm以下,660 nm激光并未激发小檗碱。而小檗碱与PDT联合抑菌可能是小檗碱与亚甲基蓝产生了协同作用。此外,治疗顺序是影响PDT与抗生素联合治疗效果的重要因素。关于联合应用的疗效,先前的报道有相互矛盾的结果,Ronqui等[26]结果表明,先抗生素后PDT比先PDT后抗生素的抑菌效果更好。Oppezzo等[27]结果表明,先PDT后抗生素比先抗生素后PDT减少了6个对数的细菌增长。本实验中先PDT后小檗碱组抑制P.g效果优于先小檗碱后PDT组,实验中假设当P.g中优先加入小檗碱再进行PDT时,小檗碱会影响亚甲基蓝的吸收峰,当用660 nm激光照射小檗碱与亚甲基蓝混合物时,会降低亚甲基蓝介导PDT的抑菌效果。经过测量发现,小檗碱的吸收峰值在400 nm以下,而亚甲基蓝在300、600 nm左右各有吸收峰值出现。当两者混合时,小檗碱并未影响亚甲基蓝在660 nm附近的吸收峰。因此,实验中假设似乎并未成立。先前有关联合使用的报道给出了一些原因,其中一种原因可能为首先应用PDT可能会导致细胞壁损伤以增加抗生素的吸收,从而增强整体抗菌效果。研究表明,用PDT预处理金黄色葡萄球菌生物膜,然后给予低于最小抑菌浓度的万古霉素,会导致生物膜基质破坏,从而几乎可以完全杀死细菌[28]。另一种原因可能为细菌的外排泵将亚甲基蓝排出,但小檗碱会产生外排泵抑制剂的效果,从而增强PDT的效果[29]。研究表明,当甲苯胺蓝与不同的外排泵抑制剂如NorA和Mex-AB共同孵育时,PDT在金黄色葡萄球菌和铜绿假单胞菌中的杀菌效果显著增加[30],且甲苯胺蓝竞争性结合外排泵抑制剂的泵结合位点。因此,需要更多的研究来明确应该采取哪种方法以获得最佳治疗效果。
综上所述,亚甲基蓝介导的PDT对P.g有抑制作用;当与小檗碱联合应用时,对P.g有协同抑制作用,且联合应用中先PDT后小檗碱作用时抑菌效果更好,为PDT与小檗碱联合应用在牙周病的治疗提供依据。未来的研究可以进一步深入探究该联合应用的治疗机制、最佳治疗方案以及对牙周组织的影响,从而为其临床应用提供更加科学、有效的依据。
所有作者均声明不存在利益冲突





















